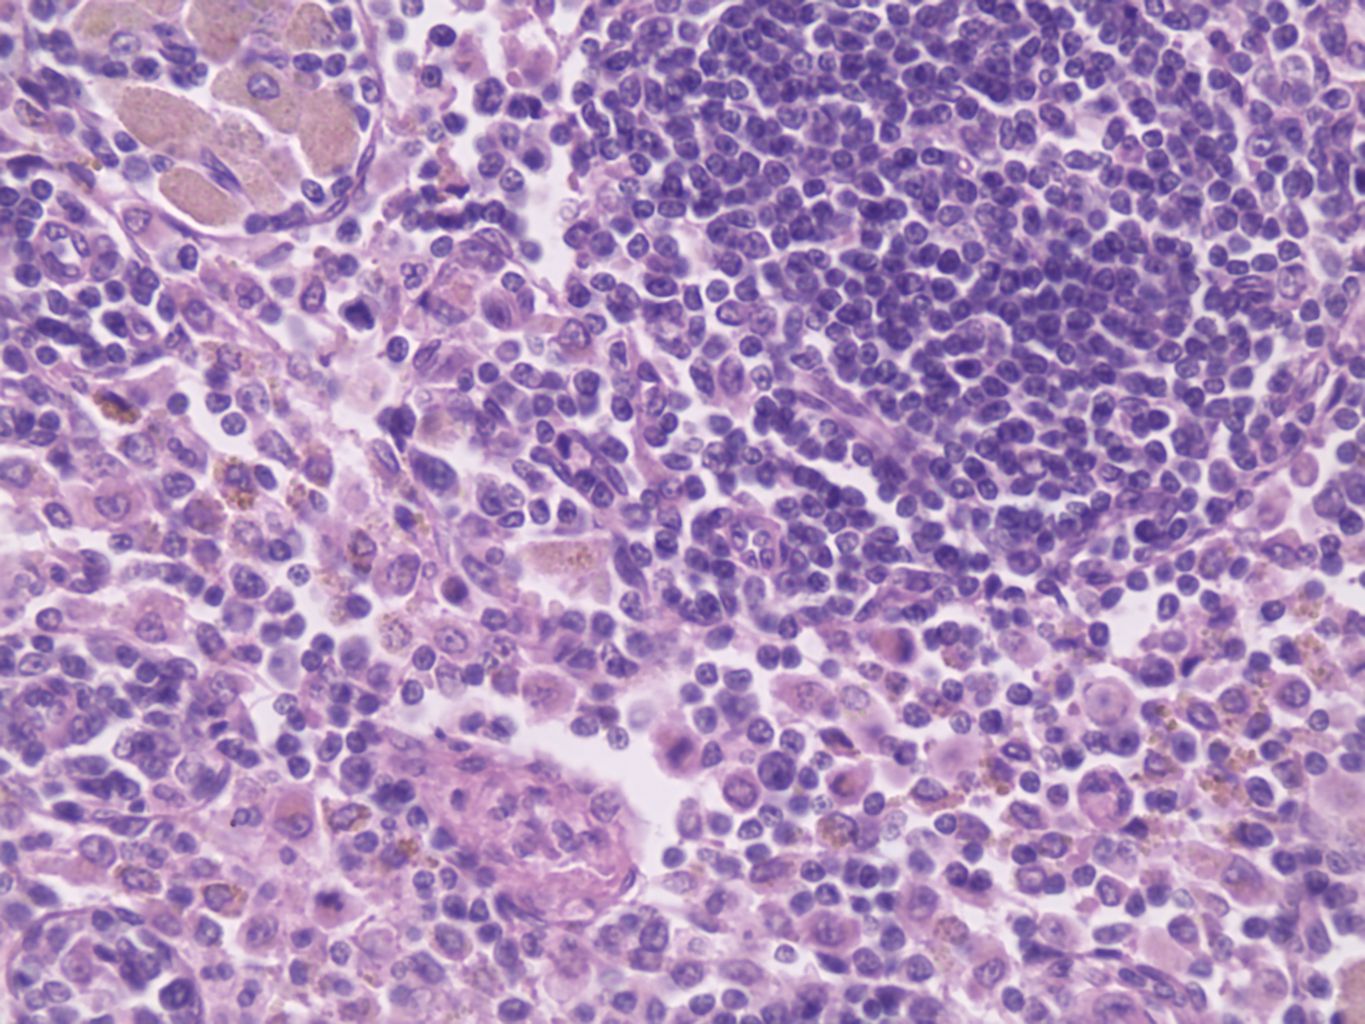

Lymph Node (Sect) H&E (Human) ,Each
$ 6.39
|
|
Details:
LYMPH NODE (SECT) H/E (HUMAN)
Additional Information
| SKU | 23379456 |
|---|---|
| UOM | EACH |
| UNSPSC | 60121605 |
| Manufacturer Part Number | WARD470183-022 |
| Product Dimensions | 3X0.05X1 Inches |
| Product Weight | 0.05 |
